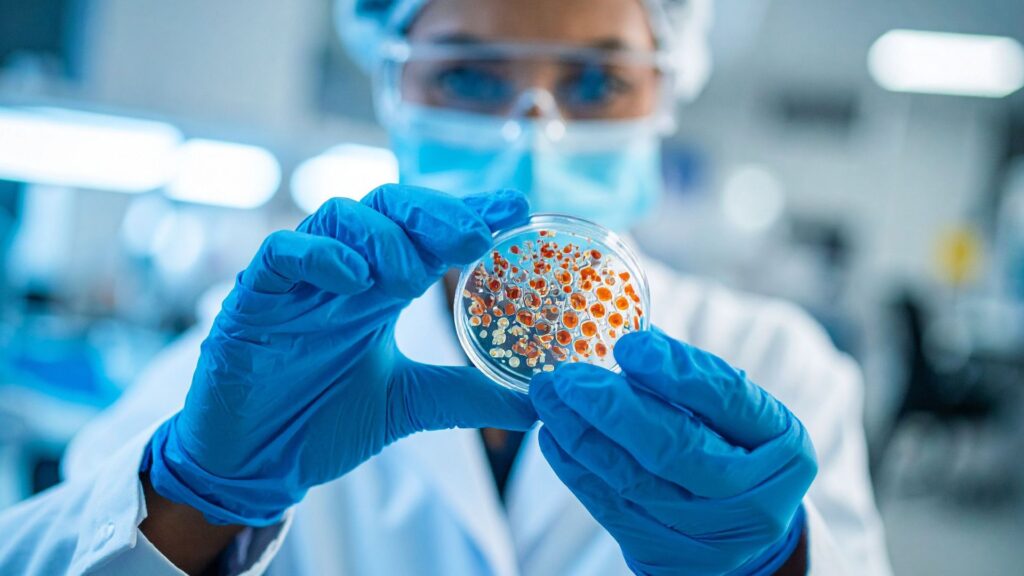

細胞生物学– category –
-

NMDA受容体とは? 記憶の仕組み「LTP」と脳の可塑性を徹底解説。最新のアルツハイマー病研究まで
I. はじめに:NMDA受容体、脳の「学習スイッチ」 私たちの脳が行う最も驚くべき機... -

In vitro(イン・ビトロ)とは?:試験管からオルガノイドまで、その意味と歴史、in vivoとの違いを徹底解説
【本レポートの概要】 科学ニュースや医療の話題において、「in vitro(イン・ビト... -

細胞培養とは?その歴史、種類、iPS細胞やオルガノイドまで専門家が徹底解説
1. はじめに:細胞培養とは何か? — 体の外で「生命」を育てる技術 現代の医学研究... -

シナプス可塑性とは?:記憶の仕組みからAIの未来まで、全メカニズムを一挙解説
第1部:シナプス可塑性の基礎 — 脳はなぜ「変わる」のか 1.1. シナプス可塑性とは... -

GLUT4とは?血糖値を下げる仕組みから最新研究まで徹底解説
第1章 はじめに - 体の血糖値マスターレギュレーター 私たちの体は、生命活動の主... -

生体組織透明化技術のすべて:生命の内部構造を3Dで解き明かす科学
はじめに:顕微鏡スライドを超えて - 生物学の新たな視界 一世紀以上にわたり、生... -

オルガノイドとは?徹底解説:作り方から最新研究、再生医療への応用まで
第1部 オルガノイド入門:「シャーレの中の臓器」の夜明け 1.1. オルガノイドとは... -

細胞培養の最先端技術 | 2Dから3D、オルガノイド、培養肉まで歴史と未来を完全解説
はじめに:細胞培養とは?生命科学を支える基盤技術 細胞培養とは、生物の体から細... -

黒光りの生存戦略:メラニズムの謎を解く。遺伝子から進化まで一挙解説
序論:黒豹(ブラックパンサー)の謎 漆黒の体毛、しなやかな筋肉、そして闇に紛れ... -

【最新版】FACS(蛍光活性化セルソーティング)完全ガイド:原理から最新技術、AI活用まで一挙解説
なぜFACSは生命科学に革命をもたらしたのか? 免疫システムやがん組織のような複雑...